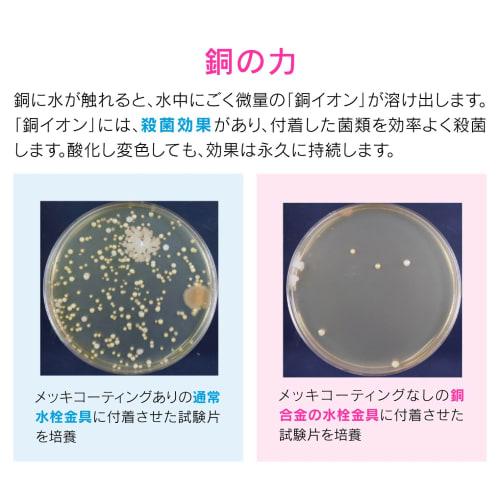
Gaona Sink Drain Replacement Set for 8cm Sinks, Antibacterial Copper Cover, Garbage Disposal, Suitable for Rentals and Mini Kitchens (GA-PB046)

The website doesn't support your browser. Please update your browser or download a different one
Gaona Sink Drain Replacement Set for 8cm Sinks, Antibacterial Copper Cover, Garbage Disposal, Suitable for Rentals and Mini Kitchens (GA-PB046)
Current price
Price €76VAT included
Delivering across 🇦🇹 Austria
Delivery 10‑31 business days
Your payments and privacy are safe









Similar products